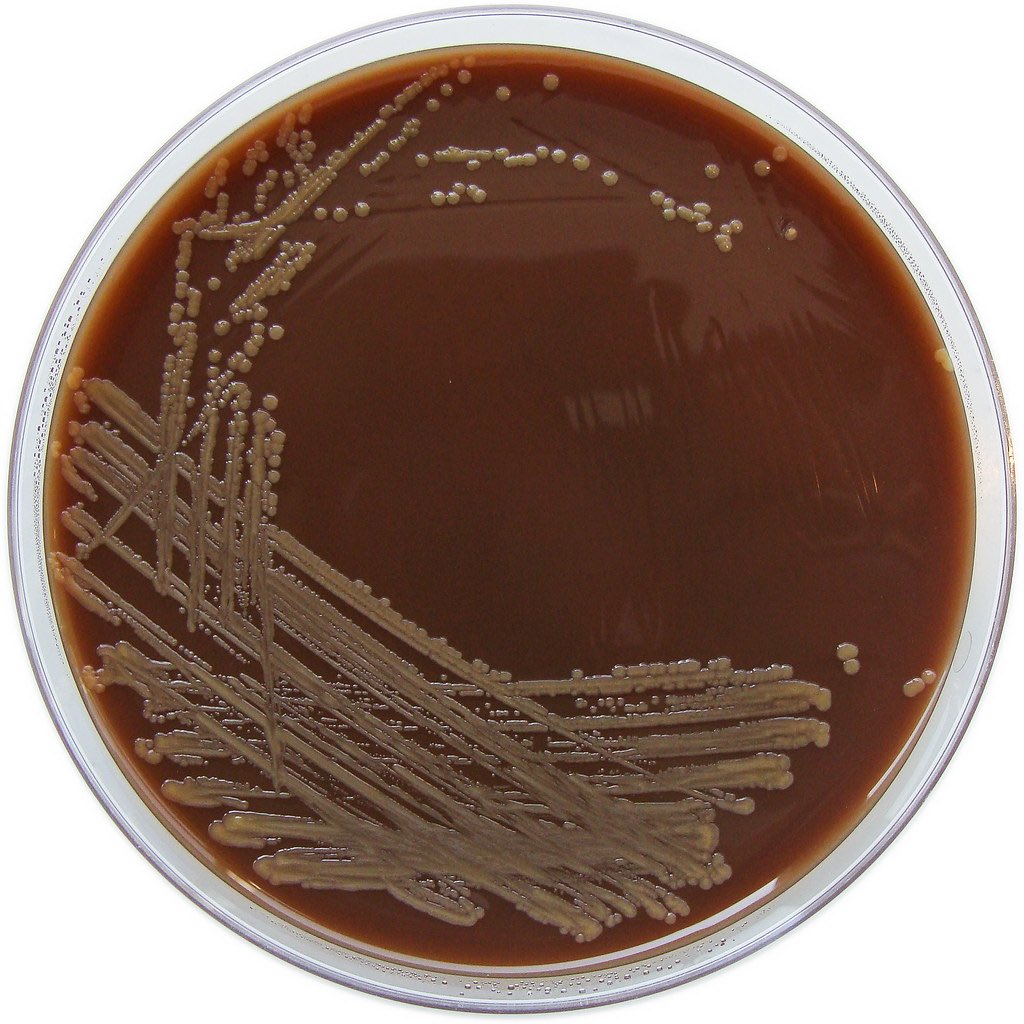

لو البكتيريا اختزلت الnitrateمعناه صار عندي nitrite الي راح يتفاعل مع
sulfanilic acid ويعطيني
nitrite-sulfanilic acid complex
بينما لو ما كانت تختزل الnitrate يعني بيضل نفس ماهو ماراح يتحول لnitrite بالتالي ماراح يصير تفاعل معsulfanilic acidبالتالي مابيتكون الcomplex
sulfanilic acid ويعطيني
nitrite-sulfanilic acid complex
بينما لو ما كانت تختزل الnitrate يعني بيضل نفس ماهو ماراح يتحول لnitrite بالتالي ماراح يصير تفاعل معsulfanilic acidبالتالي مابيتكون الcomplex
جاري تحميل الاقتراحات...